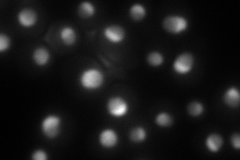

View description
Constituent of 66S pre-ribosomal particles, required for large (60S) ribosomal subunit biogenesis; involved in nuclear export of pre-ribosomes; required for maintenance of dsRNA virus; homolog of human CAATT-binding protein
Localization:
Intensity:
Fold change:
Significance:
-
C’ GFP library in SD

nucleolus77.45 -
N' NOP1pr-GFP in SD

nucleolus130.65 -
N' TEF2pr-mCherry in SD
nucleus,nucleolus121.714 -
N' NATIVEpr-GFP in SD

nucleus,nucleolus106.18 -
N' TEF2pr-VC and Cyto-VN in SD

nucleus,nucleolus47.1899 -
C’ GFP library in SD+DTT

nucleolus54.620.7No -
C’ GFP library in SD+H2O2

nucleolus98.561.27No -
C’ GFP library in Starvation Media

nucleolus33.120.42Yes -
C’ GFP library on the background of Pup2-DaMP

nucleolus -
C’ GFP library on the background of CCT mutant

nucleolus81.26941.04928No
